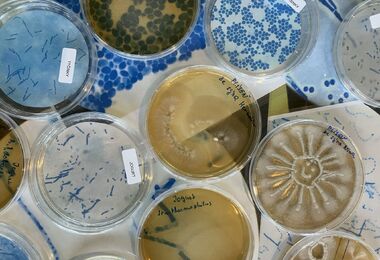
Neviditelní hrdinové kolem nás 11. a 12. 11. 2026

NZM Praha
Tematické dopoledne pro školy
Na houbách 23. 9. 2026
Jsou houby na houby? Houby s octem! Vydejte se na jedinečnou Mycological Mystery Tour, kde objevíte houby na místech, na nichž byste je vůbec nehledali. Jsou totiž všude kolem nás a vytvářejí neviditelnou síť, která propojuje svět a drží ho pohromadě. 6. třída ZŠ,7. třída ZŠ,8. třída ZŠ,9. třída ZŠ,Střední škola